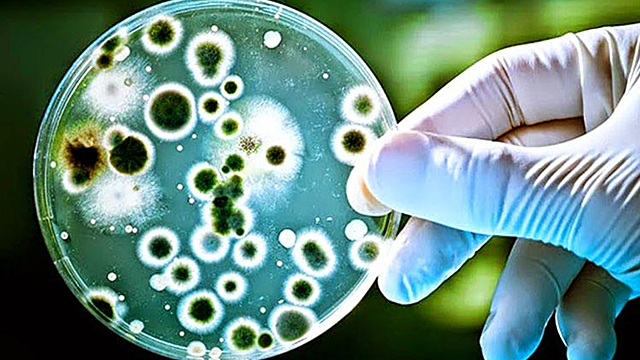
La penicilina y los microrganismos

-
La sociedad humana primitiva inicia la domesticación de plantas y animales dando lugar a la agricultura.
-
Se uso por primera vez en Egipto para la elaboración de cerveza y pan usando, usando la fermentación por medio de levaduras.
-
En este año se creó el primer insecticida natural a partir de la flor crisantemo, ya que cuenta con componentes piretrinas. También es usado en medicina para inhibir bacterias.
-
En China y Medio Oriente se obtienen bebidas alcohólicas y producción de lácteos a partir de la fermentación del grano fermentado.
-
El británico Robert Hooke descubre la célula a partir de un tejido vegetal.
-
Antonie Van Leeuwenhoek conocido por ser el padre de la microbiología descubre las bacterias, la levadura y los glóbulos de la sangre.
-
Este gran científico identifico que los microbios son la causa de la fermentación. Fundo la ciencia de la microbiología, invento el proceso de la pasteurización y desarrollo vacunas para diferentes enfermedades incluida la rabia a través de microbios.
-
Desde este punto la evolución se convierte en el unificador fundamental de la biología, de este modo Charles Darwin publicó la teoría de la evolución por la selección natural.
-
Mendel postuló las leyes de la herencia donde se aísla por primera vez el ADN.
-
Pasteur desarrolla el proceso de la pasteurización como mecanismo para la protección de los alimentos frente a los microbios peligrosos.
-
Gregor Mendel descubre en los guisantes las unidades fundamentales de la herencia.
-
Con base a la teoría de la evolución de Darwin se realizan un cruzamiento entre plantas de algodón desarrollando variedades con mayor supervivencia.
Se inculca por primera vez bacterias fijadoras de nitrógeno en los campos para mejorar la productividad de los cultivos. -
Las unidades fundamentales de la herencia biológica reciben el nombre de genes.
-
Morgan demuestra que los genes se encuentran en los cromosomas.
-
El bacteriólogo Alexander Fleming descubre la penicilina como antibiótico.
-
Laibach desarrolla la metodología conocida hoy en día como hibridación vegetal que consiste en un tratamiento para plantar una nueva planta o generación con características especiales.
-
Por primera vez en los Estados Unidos se ofrece gran variedad de maíz hibrido.
-
A partir de este año se empieza una producción rápida y a gran escala de la penicilina con ayuda de microorganismos.
-
Se halla que cada gen codifica una proteína
-
Se identifican 23 pares de cromosomas en las células del cuerpo humano la mitad proviene de la madre y la otra mitad del padre
-
Nuevas variedades del trigo fueron incrementadas en el 70%, y la revolución en la agricultura mundial, la 1 enzima de restricción que corto las moléculas el ADN propios
-
Se usa una ligasa de ADN por primera vez y este se unió por los fragmentos del ADN se creo la 1 molécula del ADN en el laboratorio de genes de una especie se introduce otra y así su funcionamiento es correctamente.
-
Fue de una bacteria cuyo nombre fue E.coli diseñada de la técnica del ADN recombinante
-
Se produce por primera vez la insulina humana y hormonas de crecimiento a partir de todas las bacterias transgénicas
Looking for a timeline maker?
Create timelines for projects, roadmaps, history, lessons, legal cases, and stories with Timetoast. Timetoast is a timeline maker for work, school, research, and stories.